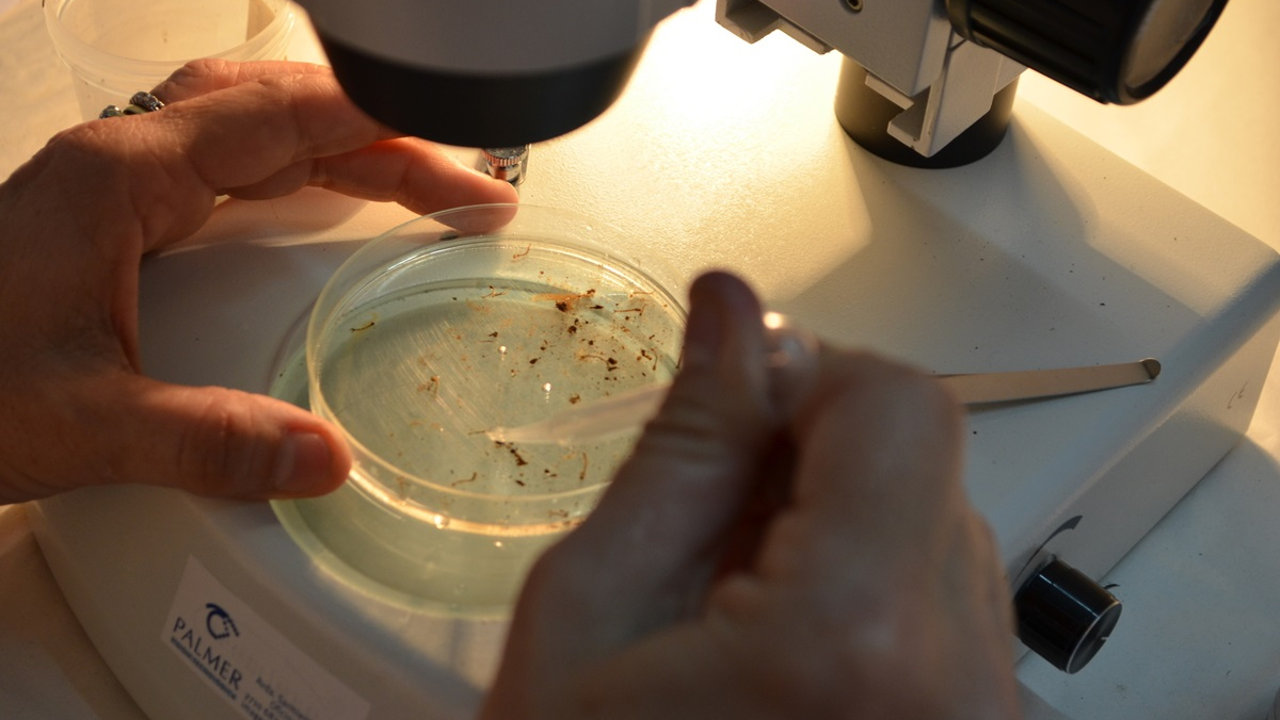
Airfind news item

Shaping Indonesia’s path towards zero dengue deaths by 2030
Published on March 30, 2026.
The Indonesian Ministry of Health led consultations to develop the “Rencana Aksi Nasional Pengendalian Dengue 2026–2029”, the national action plan for dengue. The process involved representatives from national and subnational government agencies, professional associations, United Nations partners, academics, civil society and philanthropic organizations. The plan aims to address issues such as late detection, limited diagnostic capacity, difficulties in coordination, and low community participation in dungue prevention activities. It aligns with Indonesia’s Health Transformation Agenda and the WHO Global Arbovirus Initiative, advancing malaria control, patient care and stakeholder involvement.


